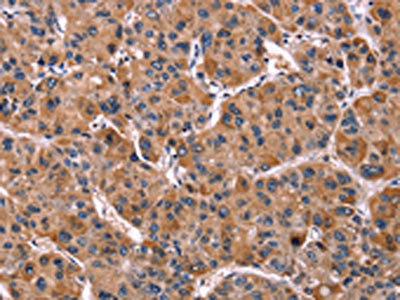

-
中文名稱:LILRB1兔多克隆抗體
-
貨號:CSB-PA184311
-
規格:¥1100
-
圖片:
-
The image on the left is immunohistochemistry of paraffin-embedded Human gastic cancer tissue using CSB-PA184311(LILRB1 Antibody) at dilution 1/50, on the right is treated with fusion protein. (Original magnification: ×200)
-
The image on the left is immunohistochemistry of paraffin-embedded Human liver cancer tissue using CSB-PA184311(LILRB1 Antibody) at dilution 1/50, on the right is treated with fusion protein. (Original magnification: ×200)
-
-
其他:
產品詳情
-
Uniprot No.:
-
基因名:
-
別名:CD85 antibody; CD85 antigen antibody; CD85 antigen like family member J antibody; CD85 antigen-like family member J antibody; CD85j antibody; CD85j antigen antibody; Ig like transcript 2 antibody; ILT 2 antibody; ILT-2 antibody; ILT2 antibody; immunoglobulin like transcript 2 antibody; Immunoglobulin-like transcript 2 antibody; leukocyte Ig like receptor 1 antibody; Leukocyte immunoglobulin like receptor 1 antibody; leukocyte immunoglobulin like receptor subfamily B member 1 antibody; Leukocyte immunoglobulin like receptor subfamily B member 1 precursor antibody; leukocyte immunoglobulin like receptor subfamily B member 1 soluble isoform antibody; leukocyte immunoglobulin like receptor, subfamily B, member 1 antibody; Leukocyte immunoglobulin-like receptor 1 antibody; Leukocyte immunoglobulin-like receptor subfamily B member 1 antibody; leukocyte immunoglobulin-like receptor subfamily B member 1 soluble isoform antibody; leukocyte immunoglobulin-like receptor, subfamily B (with TM and ITIM domains), member 1 antibody; LILRB1 antibody; LIR 1 antibody; LIR-1 antibody; LIR1 antibody; LIRB1_HUMAN antibody; MIR 7 antibody; MIR-7 antibody; MIR7 antibody; Monocyte/macrophage immunoglobulin like receptor 7 antibody; Monocyte/macrophage immunoglobulin-like receptor 7 antibody; PIR B antibody; PIRB antibody
-
宿主:Rabbit
-
反應種屬:Human
-
免疫原:Fusion protein of Human LILRB1
-
免疫原種屬:Homo sapiens (Human)
-
標記方式:Non-conjugated
-
抗體亞型:IgG
-
純化方式:Antigen affinity purification
-
濃度:It differs from different batches. Please contact us to confirm it.
-
保存緩沖液:-20°C, pH7.4 PBS, 0.05% NaN3, 40% Glycerol
-
產品提供形式:Liquid
-
應用范圍:ELISA,IHC
-
推薦稀釋比:
Application Recommended Dilution ELISA 1:2000-1:5000 IHC 1:50-1:200 -
Protocols:
-
儲存條件:Upon receipt, store at -20°C or -80°C. Avoid repeated freeze.
-
貨期:Basically, we can dispatch the products out in 1-3 working days after receiving your orders. Delivery time maybe differs from different purchasing way or location, please kindly consult your local distributors for specific delivery time.
-
用途:For Research Use Only. Not for use in diagnostic or therapeutic procedures.
相關產品
靶點詳情
-
功能:Receptor for class I MHC antigens. Recognizes a broad spectrum of HLA-A, HLA-B, HLA-C, HLA-G and HLA-F alleles. Receptor for H301/UL18, a human cytomegalovirus class I MHC homolog. Ligand binding results in inhibitory signals and down-regulation of the immune response. Engagement of LILRB1 present on natural killer cells or T-cells by class I MHC molecules protects the target cells from lysis. Interaction with HLA-B or HLA-E leads to inhibition of FCER1A signaling and serotonin release. Inhibits FCGR1A-mediated phosphorylation of cellular proteins and mobilization of intracellular calcium ions. Recognizes HLA-G in complex with B2M/beta-2 microglobulin and a nonamer self-peptide. Upon interaction with peptide-bound HLA-G-B2M complex, triggers secretion of growth-promoting factors by decidual NK cells. Reprograms B cells toward an immune suppressive phenotype.
-
基因功能參考文獻:
- single nucleotide polymorphism is associated with increased carotid intimal media thickness in renal transplant recipients PMID: 28987961
- MAFG is a direct target gene of miRNA-7.The direct regulation of MAFG through miR-7 and their involvement in the development of cisplatin resistance in human tumor cells. PMID: 29158814
- Results show that LILRB1 rs41308748:AA predisposed to the endometriosis and its progression. PMID: 29234882
- results suggest that P. falciparum has acquired multiple RIFINs to evade the host immune system by targeting immune inhibitory receptors, as LAIR1 and LILRB1 PMID: 29186116
- The exosomes-containing miR-7-5p is a crucial mediator of bystander autophagy. PMID: 27417393
- we confirmed that the RASSF2-PAR-4 axis was mainly responsible for miR-7 functions in CAFs using bioinformatics methods. Overexpression of miR-7 in CAFs led to down-regulation of RASSF2, which dramatically decreased the secretion of PAR-4 from CAFs and then enhanced the proliferation and migration of the co-cultured cancer cells. PMID: 27901488
- The miR-7 can inhibit the activation of ERK/MAPK signaling pathway by down-regulating FAK expression, thereby suppressing the proliferation, migration and invasion of NSCLC cells. The miR-7 and its target gene FAK may be novel targets for the diagnosis and treatment of NSCLC. PMID: 27764812
- Serum miR-7 was significantly elevated in the T2DM patients [(401.0+/-34.37) fmol/L, P<0.001] and in the T2DMC patients [(501.4+/-81.69) fmol/L, P<0.001] when compared with the controls [(175.7+/-16.59) fmol/L]. PMID: 28646700
- LILRB1 is used for immune evasion by Plasmodium falciparum by associating with RIFINs. PMID: 29186116
- Data indicate the MHC class I-LILRB1 signaling axis as an important regulator of the effector function of innate immune cells. PMID: 29180808
- RT-PCR analysis of serum samples confirmed that miR-7-5p and miR-26b-5p were upregulated in the serum of left ventricular hypertrophy hypertensive patients compared with healthy subjects. Our findings suggest that these miRNAs may play a role in the pathogenesis of hypertensive left ventricular hypertrophy and may represent novel biomarkers for this disease. PMID: 29069223
- LILRB1 ligation during the differentiation of monocytes to dendritic cells in vitro results in increased ABIN1 expression. ABIN1 mediates the effects of LILRB1 ligation-induced inhibitory effects on immune responses. PMID: 27129285
- the results support that a regulated assembly of these noncanonical HLA-I conformers during the immune response may enhance the avidity of their interaction with LILRB1. PMID: 27109306
- miR7 negatively regulates PAK1 protein expression but has no effect on PAK1 mRNA expression. Knockdown of PAK1 expression markedly suppressed thyroid cancer cell proliferation, migration and invasion. PMID: 27430434
- this study shows that in the tuberculosis with pleural effusion -PE cases, ILT-2 expressing cells are reduced at the local disease site PMID: 26776460
- this study shows that elevated levels of plasmatic sILT2 are present in non-muscle-infiltrating bladder cancer patients PMID: 26874236
- a woman's heterozygosity in HLA-G and LILRB1 might be an advantage for a success of reproduction, but the partner's heterozygosity in 9A/10A KIR2DL4 alleles might not PMID: 26973020
- Surprisingly, the ability of LIR1(+) natural killer cells to control virus spread differed between human cytomegalovirus strains, and this phenomenon was dependent on amino acid sequences within the viral ligand UL18. PMID: 26739048
- LIR-1 expression on CD8+ T cells in Rheumatoid Arthritis patients was higher than that in healthy controls. PMID: 26314621
- One SNP in LILRB1 (5724G>A) influenced the risk of NSCLC. 5724G>A was associated with protection from tumor cell infiltration of regional lymph nodes. Expression in tumor tissue correlated with tumor stage. PMID: 25855135
- Our findings offer new insights into the immunopathology of rheumatoid arthritis(RA) patients with long-lasting anti-RA-treatment and highlight the importance to also measure the binding capability of sHLA-G to LILRB1 PMID: 25853899
- Increased frequency of ILT2-expressing CD56(dim)CD16(+) NK cells correlates with disease severity of pulmonary tuberculosis. PMID: 24909369
- MiR-7, inhibited indirectly by lincRNA HOTAIR, directly inhibits SETDB1 and reverses the Epithelial-mesenchymal transition of breast cancer stem cells by down regulating the STAT3 pathway PMID: 25070049
- Patients expressing high levels of CD85j had an impaired ability to lyse triple negative breast cancer cells in the presence of Cetuximab. We also found that CD85j overexpression was associated with HLA-I and soluble HLA-G expression by tumors. PMID: 25726929
- Binding of specific AP-1 factors, we found JunD associated with the LILRB1 distal promoter. PMID: 24038602
- These data show that S100A9 protein, through ligation with CD85j, can stimulate the anti-HIV-1 activity of NK cells. PMID: 24156302
- To escape antiviral response, antibody-opsonized dengue virus coligates LILRB1 to inhibit FcgammaR signaling for type-I IFN-stimulated gene expression. PMID: 24550301
- This B cell regulatory mechanism involving ILT2-HLA-G interaction brings important insight to design future B cell-targeted therapies aimed at reducing inappropriate immune reaction in allotransplantation and autoimmune diseases. PMID: 24453251
- these results suggest that ILT2 participates in the defective immune-regulation observed in patients with systemic lupus erythematosus. PMID: 23756160
- MiR-7 is a novel miRNA with tumor suppressive function in colon cancer by targeting oncogenic YY1. PMID: 23208495
- HLA-G5 could be responsible, at least in part, via its interaction with ILT2, for decidual T cell IL-4 production, known to be crucial for successful pregnancy. PMID: 23997222
- miR-7 efficiently silenced some genes involved in the epidermal growth factor receptor (EGFR) pathway and achieved favorable effects in treating glioma in vivo and in vitro PMID: 23404538
- Cis association of leukocyte Ig-like receptor 1 with MHC class I modulates accessibility to antibodies and HCMV UL18. PMID: 23348966
- study concludes LIR-1 alone does not directly influence NK-cell-mediated cytotoxicity against multiple myeloma (MM); work provides investigation of inhibitory capability of LIR-1 in NK-92-mediated cytotoxicity against MM and the functional evaluation of LIR-1 on MM and LBCL lymphoblastoid cell line PMID: 22844324
- A significant correlation was identified between miR-7 expression and tumor grade in high-risk ER+ breast cancer. PMID: 22623953
- expression of CTLA-4 and LIR-1 by peripheral T. cruzi antigen-responsive IFN-gamma-producing and total T cells from chronically T. cruzi-infected subjects with different clinical forms of the disease PMID: 22574131
- The carriage of the HLA-G minus 14-bp polymorphism, LILRB1 single nucleotide polymorphism rs1061680, and activating and inhibitory KIRs are different in different ethnic groups but generally is not correlated with susceptibility to HIV-1. PMID: 22296096
- The expression of CD85j, NKG2D, NKp30, NKp44, KIR2DL1/S1 and KIR2DL2/L3/S2 receptors at the cell surface evolves between 8 and 12 weeks of gestation. PMID: 22242197
- [review] This review of LILR during HIV-1 infection focuses on the dynamic interplay between LILR and HLA class I molecules in determining HIV-1 disease progression, and the effects of HIV-1 mutational escape on LILR-mediated immune recognition. PMID: 22028331
- Association of overt and subclinical atherosclerotic disease with LILRB1+ NK and T-cells reflects a relationship between the immune challenge by infections and cardiovascular disease risk, without attributing a dominant role for human cytomegalovirus. PMID: 21817101
- The rate of HLA-G receptor ILT-2 on CD4(+)T cell, CD8(+)T cell and B cell in acute rejection group was statistically lower than that in stable kidney function group after renal transplantation. PMID: 21092455
- The abnormal expression and function of ILT2 detected in autoimmune thyroid disease suggests that this receptor may participate in the pathogenesis of this condition. PMID: 21551166
- High affinity soluble ILT2 receptor is a potent inhibitor of CD8(+) T cell activation. PMID: 21213105
- show that mAb 256 does not target a TCR ligand but blocks key interactions between non-TCR molecules on effector gammadelta T cells and ILT2 molecule, expressed by tumor targets PMID: 21233315
- LILRB1 exhibits a lower binding affinity for a subset of HLA-A alleles expressed by myeloid cells. PMID: 21270408
- T cells require ILT2-positive cells to upregulate cell-surface ILT2 upon activation, evidence that sensitivity to modulatory molecules can be acquired from other cells. PMID: 21242521
- level of expression on NK cells varies depending on genetic polymorphism PMID: 20600445
- the proportions of CD8+ T cells displaying LILRB1, an inhibitory NKR expressed at late stages of T cell differentiation, were directly related with age and MS duration PMID: 20580616
- Blockade of LILRB1 and LILRB3 receptors by monoclonal antibodies or short interfering RNA (siRNA) abrogated the specific antigen-presenting properties of dendritic cells, implying an important regulatory role of these molecules. PMID: 20631139
- alloreactivity of a significant fraction of KIR(-) NK cells leads to killing of acute myelogenous leukemia and acute lymphoblastic leukemia blasts that is mediated by NKG2A and LIR-1. PMID: 20139023
顯示更多
收起更多
-
亞細胞定位:Cell membrane; Single-pass type I membrane protein.; [Isoform 5]: Secreted.
-
組織特異性:Expressed in B cells, monocytes and various dendritic cell (DC) subsets including myeloid, plasmacytoid and tolerogenic DCs (at protein level). Expressed in decidual macrophages (at protein level). Expressed in decidual NK cells (at protein level).
-
數據庫鏈接:
Most popular with customers
-
-
YWHAB Recombinant Monoclonal Antibody
Applications: ELISA, WB, IHC, IF, FC
Species Reactivity: Human, Mouse, Rat
-
Phospho-YAP1 (S127) Recombinant Monoclonal Antibody
Applications: ELISA, WB, IHC
Species Reactivity: Human
-
-
-
-
-